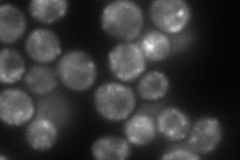
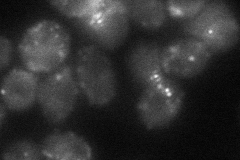

View description
Dynamin-related GTPase required for mitochondrial fission and morphology; assembles on the cytoplasmic face of mitochondrial tubules at sites at which division will occur; also participates in endocytosis and regulating peroxisome abundance
Localization:
Intensity:
Fold change:
Significance:
-
C’ GFP library in SD

punctate25.92 -
N' NOP1pr-GFP in SD

punctate70.0126 -
N' TEF2pr-mCherry in SD
punctate122.278 -
N' NATIVEpr-GFP in SD

punctate,mitochondria31.0744 -
N' TEF2pr-VC and Cyto-VN in SD
punctate46.4203 -
C’ GFP library in SD+DTT

punctate29.131.12No -
C’ GFP library in SD+H2O2

punctate23.770.91No -
C’ GFP library in Starvation Media

punctate35.91.38Yes -
C’ GFP library on the background of Pup2-DaMP

punctate -
C’ GFP library on the background of CCT mutant

punctate18.1120.698487Yes
